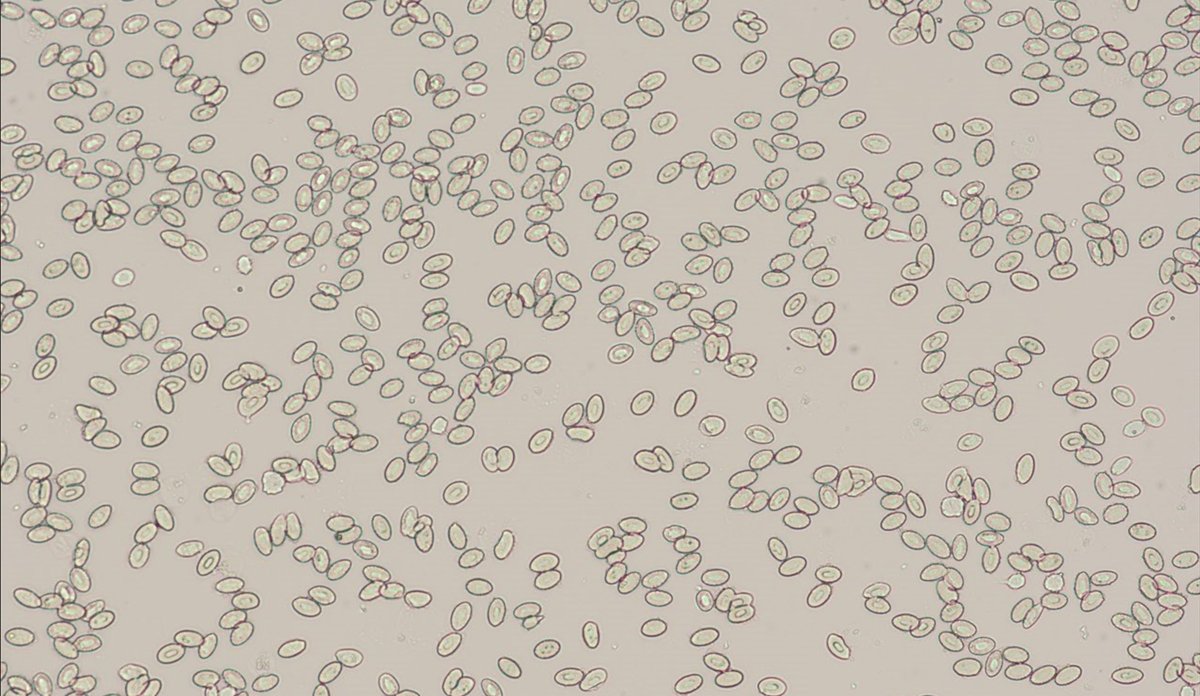

Challenges and Opportunities with Sterile Salmon

Salmon in farm.
Photo: Erling Svensen/HavforskningsinstituttetPublished: 11.11.2024
Triploid Salmon and Welfare Issues
Triploid salmon have some advantages—they lower the environmental impact of escapees, and they grow better than ‘normal’ diploid farmed salmon.
“If they escape, they cannot breed with wild salmon, reducing the genetic impact on wild populations,” explains researcher Aurélien Delaval.
The issue is that triploid salmon often have poorer health compared to non-sterile, diploid salmon.
“Triploid salmon are more prone to skeletal and heart deformities, cataracts, infectious diseases, and skin sores,” says Delaval.
Over the past decade, triploid salmon have been produced in Norway as part of commercial trials. However, production was halted in 2023 due to welfare challenges. Other countries, like Australia and Canada, continue to produce triploids commercially.
Triploid Salmon Have Larger Blood Cells
Triploid fish are created by subjecting eggs to a pressure treatment shortly after fertilization, causing them to retain an extra set of DNA.
To confirm that the salmon has an extra set of chromosomes and are indeed triploid, researchers typically take blood samples and examine the blood cells.
“Triploid salmon have larger blood cells due to the extra chromosomes, which take up more space in the cell. This size difference helps us distinguish between triploid and diploid salmon,” explains project leader Alison Harvey.
New Genetic Method Reveals Aberrant Inheritance Patterns
Researchers suspected that the health issues in some triploid fish were rooted in their genetics.
To investigate this, they developed a new genetic method as an alternative to blood sampling. This enabled them to accurately identify the genetic inheritance patterns in triploid fish following the pressure treatment.
“We used genetic markers to trace chromosome inheritance from parents to offspring,” says Harvey.
Through this method, researchers discovered that some salmon exhibited unusual inheritance patterns.
“Some fish were neither fully triploid nor diploid but had a mix—with three sets of DNA on some chromosomes but only two on others. In some cases, fish inherited DNA solely from the father, not the mother,” says Harvey.
It remains to be seen if these fish are sterile and if these unusual genetics patterns contribute to poorer health in some treated fish.
The researchers are already investigating why this happens.
“We’re examining whether the way we create triploid salmon causes some fish to exhibit genetic disorders”, says Delaval.
Pressure Treatment May Be the Cause
To test this, eggs from different salmon families were subjected to five different pressure treatments.
Here’s how it was done:
- One group of fish was not subjected to pressure and were produced as regular, diploid, non-sterile fish.
- Another group was exposed to high pressure to create triploid salmon.
- The three remaining groups were exposed to a gradient of lower pressures, simulating failed pressure treatments.

“We found that a small percentage of eggs in all groups, even those without pressure treatment, exhibited unusual inheritance patterns,” Delaval explains.
“This shows that unusual inheritance can happen naturally, as in other species, including humans.”
However, unusual inheritance patterns appeared much more frequently in the three groups with “failed” pressure treatments, and mortality rates among these eggs were higher.
This suggests that unsuccessful pressure treatments may increase abnormal inheritance patterns and mortality rates.
Further Investigation Needed
The next step is to examine if any of these eggs survive and develop into fish with genetic syndromes.
“We are continuing to monitor these fish as they grow. This will allow us to identify whether they develop deformities, reduced growth, and increased disease susceptibility, and evaluate whether this is linked to the pressure treatment,” says Delaval.
About the Project
The project is funded by the Research Council of Norway (NFR). Its goal is to investigate the genetic causes of welfare challenges in triploid salmon, including whether the commonly used pressure treatment may be a contributing factor.
Reference
Delaval, A., Glover, K.A., Solberg, M.F. et al. Chromosomal aberrations and early mortality in a non-mammalian vertebrate: example from pressure-induced triploid Atlantic salmon.